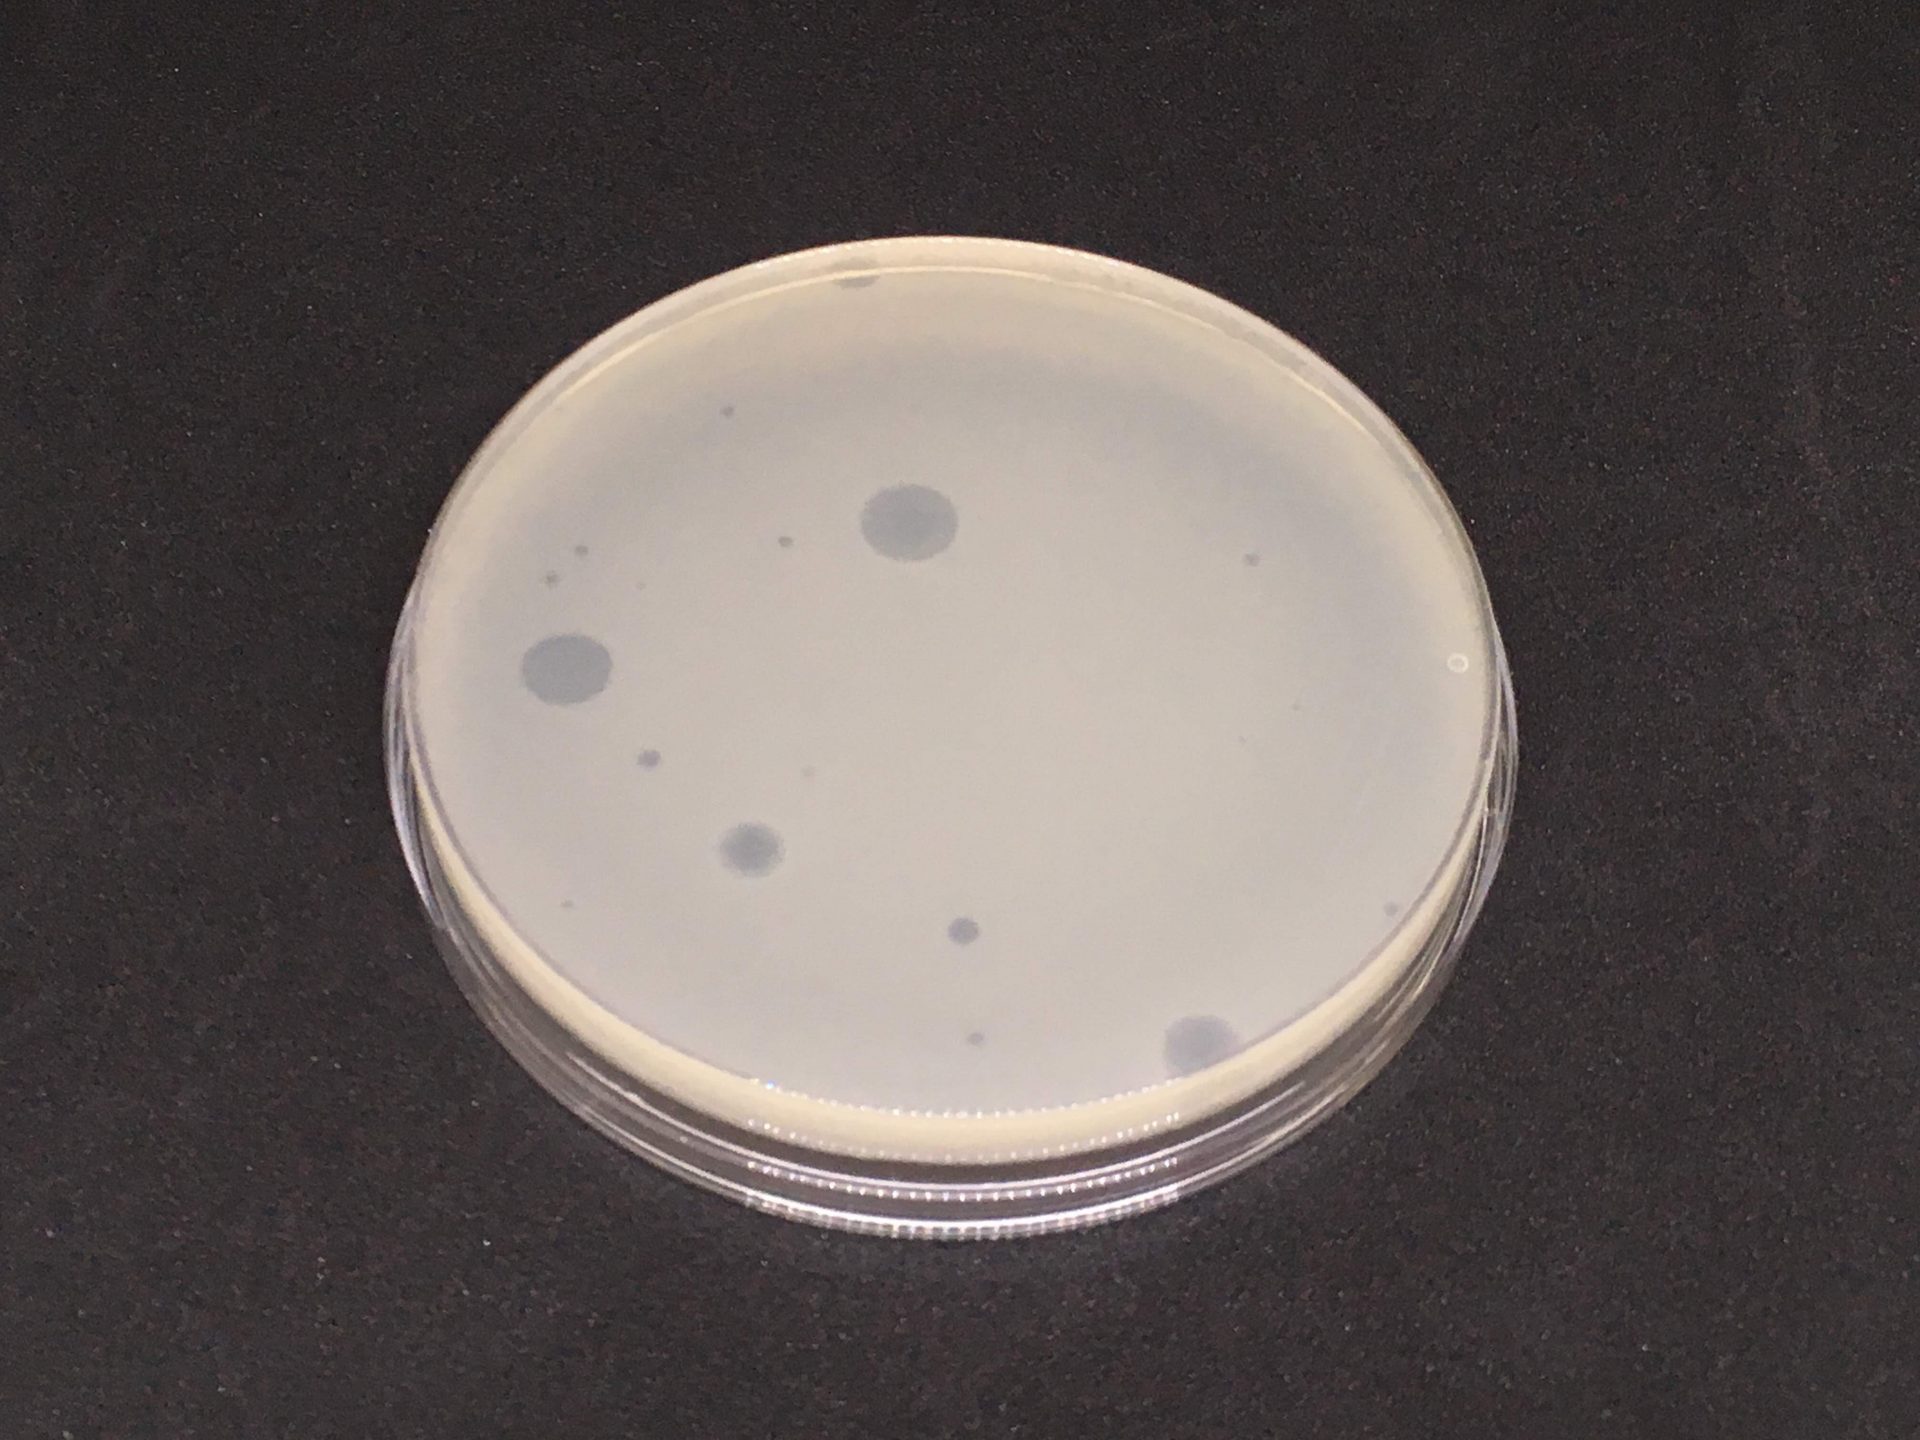
CB390PH Culture_Method_Bluephage

BLOG | Bluephage
PCR versus cultural methods to detect coliphages

In water analysis, microbes can be detected by culture methods or by molecular methods.
Culture methods are based on detecting the effects, cell lysis in the case of bacteriophages, of viral infection on susceptible host cells. Therefore, culture methods only detect live viruses.
In the case of human viruses of interest to the water industry, there are still some viruses, such as, for example, noroviruses, hepatitis A viruses, and rotaviruses, for which there are no viable methods of routine analysis. Only enteroviruses, which have been reported to grow in a few cell lines, e.g. BGM, can be viably detected by culture methods.
Application of culture methods to the detection of coliphages.
The ability of phages to infect and grow in a particular host strain is what defines somatic coliphages (E. coli C strains and the nalidixic-resistant spontaneous mutants WG5 and CN13) and F-specific coliphages (E. coli HS (Famp) and Salmonella Typhimurium WG49).
Phage counts are performed by direct quantitative plate assays, which provide results in plate-forming units (PFU). A qualitative presence-absence enrichment assay can also determine the presence of phage in a given volume of sample. Enrichment of serial dilutions in multiple tubes allows estimation of the number of phages by “quantifier” methods, such as the most probable number. Detection of lysis in a liquid medium can be detected by checking the increase in the medium of infectious phages subsequently assayed in solid medium or by the release into the medium of a specific molecule, which is the BLUEPHAGE approach.

Molecular methods
Nucleic acid amplification tests (NAATs) can detect whole genomes or genome fragments of DNA viruses (polymerase chain reaction (PCR); loop-mediated isothermal amplification (LAMP)) or RNA viruses (reverse transcription + PCR (RT-PCR), reverse transcription + LAMP (RT-LAMP) and transcription-mediated amplification (TMA)).
These methods, which require relatively sophisticated equipment, are very sensitive (a few particles) and fast (up to 2 hours). All of them can be adapted for quantification.
But the drawback of these methods, for application in the water industry, is that they detect life and dead viruses, either because they are defective particles resulting from imperfect replication or because they have been inactivated. When properly applied, the values detected by NAATs exceed those detected by the culture.
This applies to raw wastewater, and it is well known that for viruses, including bacteriophages, important in the water industry, this difference increases after disinfection treatments or after permanence in the environment. Therefore, the values obtained by NAATS are not useful for sanitary risk analysis or for evaluating the performance of treatments.
Antigen detection tests (Ag-DTs) are immunoassays that detect the presence of a specific viral antigen, usually proteins or glycoproteins, present on viral particles in a sample.
A wide variety of Ag-DTs are available. Many of them are rapid and simple and do not require sophisticated equipment but are less sensitive than NAATs. Most are qualitative, but many are also adaptable to quantification. However, like NAATs, Ag-DTs cannot distinguish between live and dead viruses and consequently have the same limitations as NAATs.
Molecular methods are not available to provide results for somatic and F-specific coliphages, as contemplated in the regulations. By definition, both groups include several bacteriophage species and even families that cannot be detected as a whole by a single molecular test. So far, no effort has been applied in this field for the detection of somatic coliphages. In contrast, qRT-PCR methods are available for the four F-specific RNA coliphage genogroups, which had been planned to be applied for microbial source tracking.
An Ag-DT assay has been adapted to detect in water samples of these F-specific RNA genogroups after enrichment.

